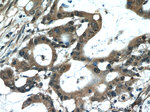
MACC1 Antibody in Immunohistochemistry (Paraffin) (IHC (P))

Search
Proteintech
MACC1 Polyclonal Antibody
{{$productOrderCtrl.translations['antibody.pdp.commerceCard.promotion.promotions']}}
{{$productOrderCtrl.translations['antibody.pdp.commerceCard.promotion.viewpromo']}}
{{$productOrderCtrl.translations['antibody.pdp.commerceCard.promotion.promocode']}}: {{promo.promoCode}} {{promo.promoTitle}} {{promo.promoDescription}}. {{$productOrderCtrl.translations['antibody.pdp.commerceCard.promotion.learnmore']}}
产品信息
21970-1-AP
种属反应
宿主/亚型
分类
类型
抗原
偶联物
形式
浓度
规格
纯化类型
保存液
内含物
保存条件
运输条件
产品详细信息
Immunogen sequence: ITTPDPTPN LKRLSNLPGY LQKKEEIKSA PLSPKILVKY PTFQDKTLNF SNYGVTLKAV LRQSKIDYFL EYFKGDTIAL LGEGKVKAIG QSKVKEWYVG VLRGKIGLVH CKNVKVISKE QVMFMSDSVF TTRNLLEQIV LPLKKLTYIY SVVLTLVSEK VYDWKVLADV LGYSHLSLED FDQIQADKES EKVSYVIKKL KEDCHTERNT RKFLYELIVA LLKMDCQELV ARLIQEAAVL TSAVKLGKGW RELAEKLVRL TKQQMEAYEI PHRGNTGDVA VEMMWKPAYD FLYTWSAHYG NNYRDVLQDL QSALDRMKNP VTKHWRELTG VLILVNSLEV LRVTAFSTSE EV (502-852 aa encoded by BC137090)
靶标信息
MACC1 (Metastasis associated in colon cancer 1) is a key regulator of the hepatocyte growth factor (HGF)-HGF receptor (MET) pathway, which is involved in cellular growth, epithelial-mesenchymal transition, angiogenesis, cell motility, invasiveness, and metastasis. MACC1 protein consists of four domains: ZU5, SH3, and two C-terminal death domains (DD). Expression of MACC1 was found significantly upregulated in malignant tissues (colon cancer of all stages as well as liver and lung metastases) compared to normal tissues or adenomas. MACC1 represents an early and crucial prognostic indicator for colon cancer metastasis that is independent of age, sex, tumor infiltration, nodal status, and lymph vessel invasion. Besides its involvement in signal transduction with the MET receptor, MACC1 also links MET signaling and apoptosis. MACC1 may also be an important therapeutic target for colorectal cancer treatment. At least two isoforms of MACC1 are known to exist.
仅用于科研。不用于诊断过程。未经明确授权不得转售。
生物信息学
蛋白别名: MACC1, MET transcriptional regulator; metastasis associated in colon cancer 1; Metastasis-associated in colon cancer protein 1; putative binding protein 7a5; SH3 domain-containing protein 7a5; unnamed protein product
基因别名: 4732474O15Rik; 7A5; Gm267; MACC1; SH3BP4L
UniProt ID: (Human) Q6ZN28
Entrez Gene ID: (Human) 346389, (Mouse) 238455